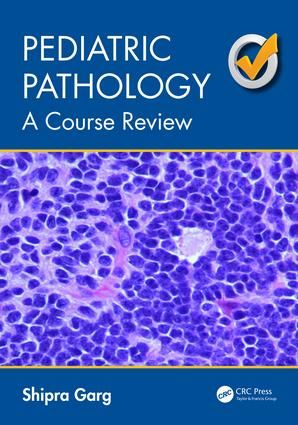
Pediatric Pathology | 1:a upplagan

Vi flyttar från butik till nätet - så funkar det framåt
Pediatric Pathology | 1:a upplagan
- Pocket, Engelska, 2016
- Författare: Shipra Garg
- Betyg:
1061
kr
Skickas inom 0-2 vardagar
Butikslager
Onlinelager
I lager hos leverantör
Fler utgåvor
Beskrivning
This book serves as a quick study guide during the stages of examination preparation for the pediatric pathology boards. The material covers most of the major topics in pediatric pathology including the fetal, perinatal, infant, child, and organ system pathology. It includes a short quiz containing 115 questions with photomicrographs for each, and an answer key inserted at the end of the book.
Om denna bok
Pediatric Pathology av Shipra Garg är en Pocket bok med 366 sidor på Engelska. Detta är den 1:a upplagan som utgavs 2016 av Taylor & Francis Ltd.
Spara pengar – köp begagnad från Campusbokhandeln
Köp Pediatric Pathology begagnad från Campusbokhandeln och spara upp till 25% jämfört med nypris. Du kan bevaka den här boken så får du ett mail så fort vi får in den i lager som begagnad.
Genom att köpa & sälja begagnat sänker du kostnaden för studier både för dig och nästa student samtidigt som du gör nytta för klimatet.
Produktinformation
Kategori:
Medicin, vård & fysiologi
Bandtyp:
Pocket
Språk:
Engelska
ISBN:
9781498723534
Upplaga:
1
Utgiven:
2016-08-22
Förlag:
Taylor & Francis Ltd
Sidantal:
366
